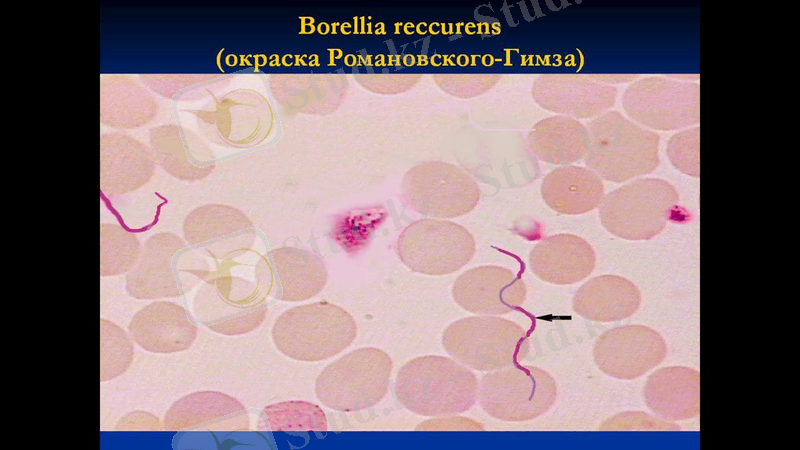
Slide 26

Микробологиялық препараттарды бояу әдістері және қолданылатын ерітінділер



Қазақстан Республикасының Білім және Ғылым министрлігі Семей қаласының Шәкәрім атындағы мемлекеттік университеті
СӨЖ
Тақырыбы: Препараттарды бояу әдістері және қолданылатын ерітінділер.
Орындаған: Куатбек М. М.
Тобы: ВМ-503
Тексерген: Нуркенова М. К.
Семей 2017

Жоспар
І. Кіріспе
ІІ. Негізгі бөлім
Бояу.
Күрделі бояу әдістер
Грам әдісі бойынша бояу механизмдері мен сатылары.
Құрал жабдықтары
ІІІ Қорытныды
Пайдаланылған әдебиеттер тізімі.

Бояу Микробтарды бояу үшін ең қолайлысы анилин бояулары, соның ішінде оның негізгі және бейтарап түрі. Қышқыл бояулар бұл үшін аса жарамды емес. Анилин бояулары ұнтақ түрінде сатылады. Одан зертханада қанықтырылған спирттік ерітінді даярлайды. Бұл осы күйінде бактерияларды бояуғажарамсыз. Осыдан жағындыны бояуға керекті сұйық ерітінділері,
яғни жұмыстық ерітінділері даярланады.














Грам әдісі бойынша бояу механизмдері мен сатылары.
Грам әдісімен бояу
Бояу этаптары.
1) Жұғын-препаратты генцианвиолетпен бояу (2 мин, фильтр қағазы арқылы) ;
2) Бояу фильтр қағазын алып тастау, қалған бояуды төгу;
3) Жұғын-препаратты Люголь ертіндімен бояу (1 мин) ;
4) Люголь ертіндісін төгіп тастау және 96% спирттің бірнеше тамшысын тамызу (30-40 сек, шыныны сәл қозғау) ;
5) Спиртті сумен жақсылап шайып тастау;
6) Сулы фуксинмен бояу (2 мин) ;
7) Сумен жақсылап шайып тастау, фильтр қағазымен құрғату;
8) Жұғын-препаратты иммерсиялық жүйе көмегімен микроскоптан қарау.
Барлық бактериялар Грам әдісімен боялуы бойынша бөлінеді: грам оң сия көкфиолет түсте және грам теріс - қызыл түсте. Осылай боялу қабілеті бактерияның химиялық құрамына байланысты. Грам оңды бактериялар клетка қабырғасында ароматты және күкіртті аминқыш-қылдары жоқ, липидтер аз, ал грам теріс бактерияларда, керісінше, аталған заттар көп мөл-шерде кездеседі. .

Кептірілген және май шам жалынында фиксирленген микроорганизмдер препаратын күлгін генциан феголының ерітіндісінде 1минут бойы бояйды. Бояуды құйып алып, препаратты сумен жумастан, оған люголия ерітіндісін қосып 1 минут (мазок толық қарайғанша ) ұстап тұрады . Препаратты (сумен жумастан ) 96 спиртте 15-20 секунт, шайқап тұрып өңдейді . Түсін өзгерту уақыты өте маңызды, белгілі мерзімнен артып кетсе грам оңның өзі ағкарып кетеді, ал препаратты өңдеу уақыты жетпей қалса қатты боялып кетеді .
Препаратты сумен жуып, гоны Пфейфера фусинімен бояйды . Грам оң микроорганизмдер қара -күлгін түске боялады, Грам теріс боялмайды.
Құралдар:

ҚЫшқылға тұрақты бактерияларды бояу
Қышқылға тұрақты микроорганизмдер бейорганикалық қышқылдарға, спиртке, сілтіге айтарлықтай тұрақтылық байқатады. Олардың осындай қасиеті клетка қабырғасында және цитоплазмасында липидтердің көп болуымен (воск тәрізді заттар) байланысты. Микобактериялар қарапайым бояуларды дұрыс қабылдамайды, сондықтан жылытылған концентрленген бояулар ертінділері қолданалады. Бояу барысында микробтық клеткаларды қышқылмен өндегенде, олар алғашқы бояуын жоймайды. Осы қасиеті бойынша басқа қышқылға тұрақсыз бактериялардан ажыратуға болады. Қышқылға тұрақты бактерияларды Циль-Нельсен әдісімен бояйды .

Циль-Нильсен әдісімен бояу

Әдістемесі:
1. фиксацияланған жұғын-препаратқа карбол фуксинің бірнеше тамшысын тамызады, фильтр қағазбен жауып бу шыққанға дейін қыздырады, тағы 1-2 рет бояу тамызып қыздырады (3-5 мин) ;
2. фильтр қағазын алып тастап, жұғын-препаратты салқындатады, 5% күкірт қышқылы ертіндісі немесе 3% соляноқышқыл спиртімен (2-4 с) түссіздендіреді;
3. жақсылап сумен шаяды;
4. Леффлер сия көгімен бояу (3-5 мин) ;
5. Сумен жақсылап шайып, кептіру керек.
6. Микросптан қарау. Қышқылға тұрақты бактериялар рубинді-қызыл түсте, ал қалғандары - сия көк түске боялады.

Барлық бактериялар Грам әдісімен боялуы бойынша бөлінеді: грам оң сия көк-күлгін түсте және грам теріс - қызыл түсте. Осылай боялу қабілеті бактерияның химиялық құрамына байланысты. Грам оң бактериялардың жасуша қабырғасында ароматты және күкіртті аминқышқылдары жоқ, липидтер аз, ал грам теріс бактерияларда, керісінше, аталған заттар көп 18 мөлшерде кездеседі. Сонымен қатар, грам оң бактерияларда рибонуклеин қышқылының магний тұздары бар, олар грам теріс бактерияларда жоқ. Осы заттар генцианвиолет, йодпен және ақуыздармен бірге тұрақты химиялық кешен құрайды, спиртпен түссіздендіргенде жойылмайды. Грам теріс бактерияларда бұндай кешен құралмағандықтан, спиртпен жылдам түссізденеді. Бірақ спиртпен өңдеу уақытын шектеу қажет, берілген уақыттан көп түссізденсе кешен бұзылуы мүмкін. Сондықтан келесі сулы фуксин бояу түсін қабылдайды. Ал егер берілген уақыттан аз спиртпен түссіздендірілген болса грам теріс бактерияларды ажырату қиынға соғады.

Волютин қосындыларын бояу
Волютин - бұл нуклеин қышқылының туындысы - қоректі зат ретінде маңызды роль атқарады. Қоректі зат ретінде майлар, гликоген және волютин ереше орын алады. Осы қосындыларды микроскопияда ажыратып алғашқы болжамды диагноз қоюға болады, мысалы, күл ауруында. Волютин дәндерін айқын Нейссер әдісімен бояғанда кӛруге болады.

Волютин дәндерін Нейссер әдісі бойынша бояу: Бояу кезеңдері: 1. Жұғын-препаратты Нейссердің сіркесу қышқылды сия кӛгімен бояу (2- 3 мин) ; 2. Сумен шайып тастау; 3. Люголь ертіндісімен бояу (30 сек) ; 4. Бояуды тӛгіп тастау және везувинмен бояу (1 мин) ; 5. Жұғын-препаратты жақсылап шайып сүзгі қағазымен кептіру. 6. Жұғын-препаратты иммерсиялық жүйемен микроскоптан қарап, талдау Жасуша цитоплазмасы қышқыл реакцияда болғандықтан сілтілі везувин бояуын қабылдайды және сары түске боялады. Волютин дәндері цинк ацетатын тығыз байланыстырғандықтан - қоныр-сия кӛк түсте, тіпті қара болады.

Күрделі бояу әдісіне жатады және мүшелерден алынған жұғын- препараттарды және қан препараттарын бояуға қолданады, сұйық фиксаторда бекіген соң, бактериялық жасушаның ядролық элементтерін және волютин дәндерін анықтау үшін қолдануға болады. Бояу үшін 1 мл суға бір тамшы алынады, рН - 7, 2. Бояу кезеңдері: 1. Петри ыдысына жұғын-препаратты тӛмен қаратып салу керек және препарат шыныға жабыспау үшін астына зат қою керек; 2. Шетінен бастап бояуды құю керек, кӛпіршік шықпау керек (1-2мин) ; 3. Сумен шайып тастау (рН 7, 2) және сүзгі қағазымен кептіру. Жас жасушалардың протоплазмасы сия кӛк-күлгін түске боялады, ядролық элементтері -қызыл-күлгін түс алады. Енді аз уақыт қышқылмен ӛндегенде бояуды қабылдаған микробтық жасушалар түссізденбейді. Осылай қышқылға тұрақты бактерияларды тұрақсыз бактериялардан ажыратуға болады. Қышқылға тұрақты бактерияларды қосымша Циль-Нельсен әдісімен 19 бояу қажет.
Романовский-Гимзе бойынша бояу

Ожешко әдісімен спораларды бояу
Бояу кезеңдері: 1. Бекітілмеген (фиксацияланбаған) жұғын-препаратқа 0, 5% хлор қышқылы тамшысын тамызады да оттың үстінде бу шыққанға дейін қыздырады (2- 3 мин) ; 2. Қышқылды тӛгіп, сумен шайып, кептіру керек; 3. Оттықтың үстінде бекітеді; 4. Циль-Нельсен әдісімен бояу (споралар - қызыл түсте, ал вегетативті формалары - сия кӛк түсте) . Толық жетілген спора бояуды ӛте қиын қабылдайды, себебі қабықшасы еш нәрсе ӛткізбейді. Грам әдісімен бояғанда спора түзуші дақыл бояуды тек микробтық жасушаның вегетативтік бӛлігі боялады, ал спора түссіз. Оның қабығының ӛткізгіштігі ыстық тұз қышқылымен ӛңдегеннен кейін немесе қыздырумен жүретін бояудың концентрирленген ерітіндісін қолданған кезде бірден жоғарылайды. Бояуды қабылдаған спора қышқылмен қайта ӛңдеу барысында, вегетативті жасушалар бірден бояуын жоғалтқан кезде түссізденбейді.

- Іс жүргізу
- Автоматтандыру, Техника
- Алғашқы әскери дайындық
- Астрономия
- Ауыл шаруашылығы
- Банк ісі
- Бизнесті бағалау
- Биология
- Бухгалтерлік іс
- Валеология
- Ветеринария
- География
- Геология, Геофизика, Геодезия
- Дін
- Ет, сүт, шарап өнімдері
- Жалпы тарих
- Жер кадастрі, Жылжымайтын мүлік
- Журналистика
- Информатика
- Кеден ісі
- Маркетинг
- Математика, Геометрия
- Медицина
- Мемлекеттік басқару
- Менеджмент
- Мұнай, Газ
- Мұрағат ісі
- Мәдениеттану
- ОБЖ (Основы безопасности жизнедеятельности)
- Педагогика
- Полиграфия
- Психология
- Салық
- Саясаттану
- Сақтандыру
- Сертификаттау, стандарттау
- Социология, Демография
- Спорт
- Статистика
- Тілтану, Филология
- Тарихи тұлғалар
- Тау-кен ісі
- Транспорт
- Туризм
- Физика
- Философия
- Халықаралық қатынастар
- Химия
- Экология, Қоршаған ортаны қорғау
- Экономика
- Экономикалық география
- Электротехника
- Қазақстан тарихы
- Қаржы
- Құрылыс
- Құқық, Криминалистика
- Әдебиет
- Өнер, музыка
- Өнеркәсіп, Өндіріс
Қазақ тілінде жазылған рефераттар, курстық жұмыстар, дипломдық жұмыстар бойынша біздің қор #1 болып табылады.



Ақпарат
Қосымша
Email: info@stud.kz